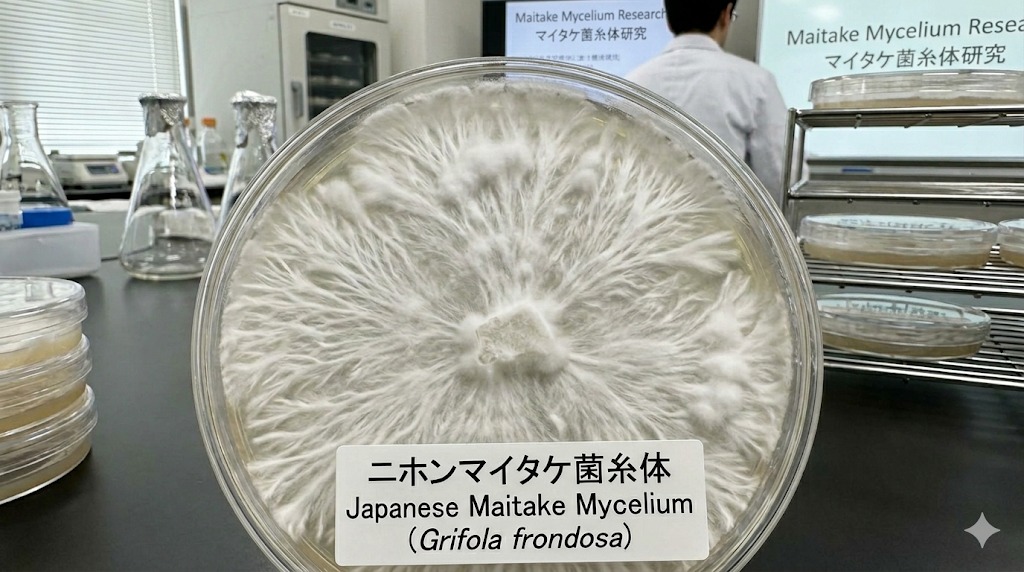
Maitake Mushroom

濕疹與鼻敏感,正喺度摧毀你哋嘅生活?
作為在職媽媽,放工返到屋企已經散晒,但真正嘅「地獄」夜晚先啱啱開始...

床單日日有血跡,睇見都心痛

怕皮膚變薄,停藥即刻大爆發

逼飲苦茶大喊大叫,心力交瘁

睡眠嚴重不足,滿滿內疚感
其實,小朋友嘅抗敏之路,絕對唔需要眼淚!


作為在職媽媽,放工返到屋企已經散晒,但真正嘅「地獄」夜晚先啱啱開始...

床單日日有血跡,睇見都心痛

怕皮膚變薄,停藥即刻大爆發

逼飲苦茶大喊大叫,心力交瘁

睡眠嚴重不足,滿滿內疚感


超過萬個家庭嘅真實選擇,小朋友當果汁開心飲,媽媽從此放心晒!


之前睇私家醫生淨係識開類固醇,停藥又爆過。阿囡半夜𢯎到床單都有血印,我真係覺得自己好失敗。飲咗兩星期 IMUGLO&TMK,紅腫退咗好多,最感動係全家終於可以瞓天光!

以前煲鱷魚肉湯或者餵中藥,成間屋好似打仗咁,阿仔喊到嘔。TMK 隻雪梨枇杷味佢竟然當果汁咁啜,仲問我可唔遇到飲多包!完全零 Effort,阿媽恩物!

囡囡又濕疹又氣管敏感,朝早起身狂打乞嚏。跟營養師教嘅「黃金交替法」,Day 1 飲 IMUGLO瞓前益生菌 ,Day 2 飲 TMK 瞓前益生菌,一個療程打通兩大防線,氣管強皮膚靚嗮!

之前阿仔全身紅到一塊塊,睇見都心噏。日日搽藥膏搞到皮膚越嚟越薄。自從朋友介紹飲咗呢套雙效配方,一個月左右已經見到紅疹退晒,而家皮膚滑溜溜,真係好感恩!
黃太 (35歲) - 擺脫3年濕疹噩夢
Karen (32歲) - 氣管敏感雙效修復
內外兼修 雙效引擎
摒棄傳統只治標嘅類固醇,採用國際專利成分,從血液細胞及根源調節免疫,非激素、零依賴。

擁有國際雙專利背書,富含超高濃度花青素。2倍速效防禦,從根源截斷過敏原。
被譽為「免疫之王」,有效增加血液免疫細胞,從內部根本調節免疫系統,非短暫壓制神經。

擁有超過400年藥用歷史的珍貴真菌,專門針對修復受損呼吸道及改善頑固皮膚問題。

傳統潤肺黃金組合,有效清除痰液與鼻涕。最重要是帶來清爽鮮甜口感,完美掩蓋草本苦味。

來自純淨深海的海洋奇蹟,擁有超強的細胞再生與修復能力。為小朋友脆弱受損的肌膚建立堅固的天然防禦牆。
INTERNATIONALLY CERTIFIED

我們明白媽媽的擔憂。產品全線通過 KKM 及 MeSTI 嚴格認證,承諾不含重金屬、無西藥成分、無激素。安全天然,長期服用絕無副作用或依賴性。
為咗達到最佳吸收率,避免身體產生耐受性,我哋為香港BB制定咗嚴格嘅日夜交替食法:

主攻血液抗炎,極速退紅腫

主攻氣管修復,清除痰與鼻涕
撕開包裝當果汁直接啜,無須沖水,方便雙職媽媽!
睇兩次私家專科嘅錢,換嚟小朋友足足4個月嘅細胞級免疫重建,以及全家人安穩嘅睡眠。
1盒Imuglo + 1盒TMK
3盒 IMUGLO + 3盒 TMK (最強性價比)
只相等於睇兩次西醫專科嘅掛號費!
今日下單,額外獲贈三大價值爆燈 Bonus:
2盒Imuglo + 1盒TMK